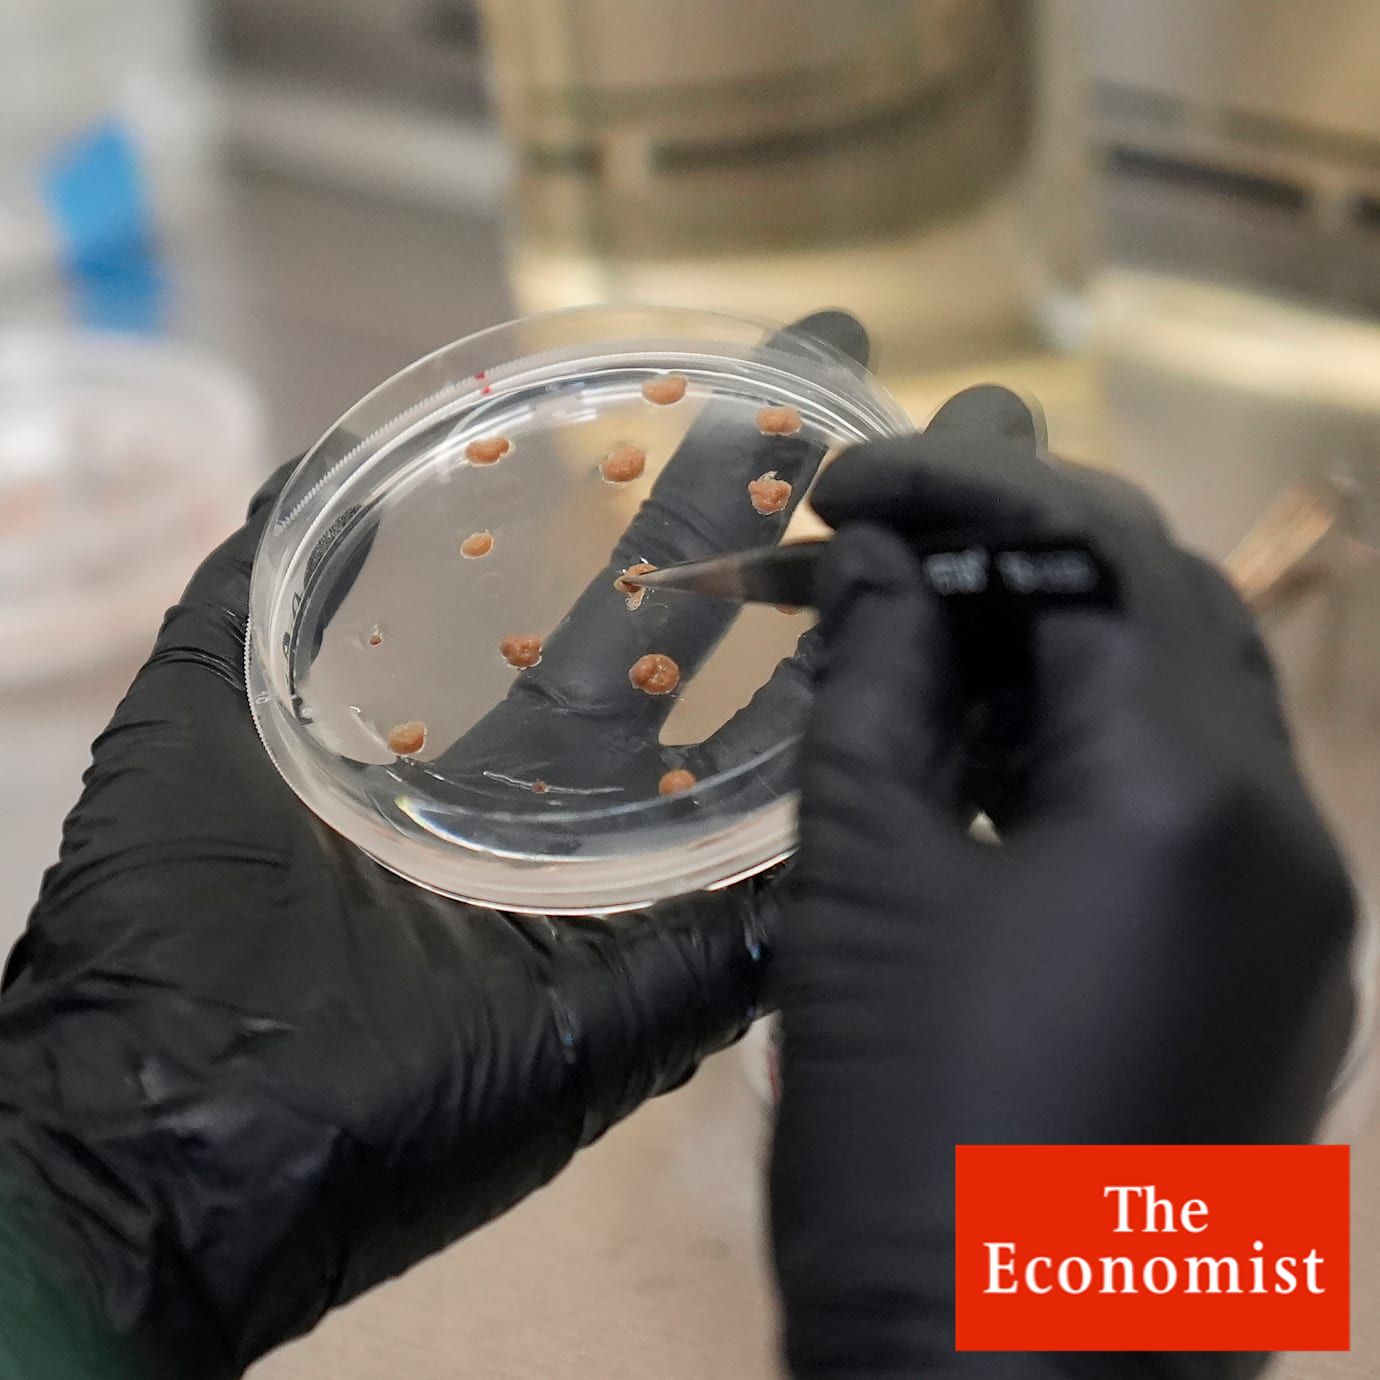

Labbodlad kakao kan bli chokladens räddning
Kakaokrisen pressar chokladjättarna till labbet. Klimatförändringar och sjukdomar har slagit hårt mot skördarna i Västafrika – och priserna på kakaobönor har tredubblats sedan 2022…
Big Chocolate has a growing taste for lab-grown cocoa
Can science solve the problem of a shortage of bea…
Få full tillgång till Omni Ekonomi
- Alla mediers affärsnyheter på ett ställe
- Upplåst innehåll från världens ledande medier
- Dagliga aktieanalyser direkt i appen
Omni är politiskt obundna och oberoende. Vi strävar efter att ge fler perspektiv på nyheterna. Har du frågor eller synpunkter kring vår rapportering? Kontakta redaktionen